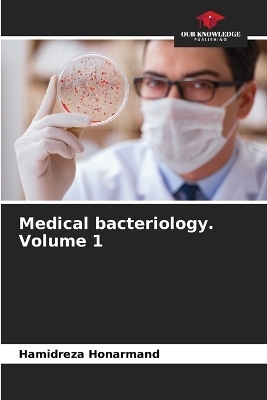
Medical bacteriology. Volume 1 - Hamidreza Honarmand

Medical bacteriology. Volume 1
Seiten
2024
Our Knowledge Publishing (Verlag)
978-620-7-50756-6 (ISBN)
Our Knowledge Publishing (Verlag)
978-620-7-50756-6 (ISBN)
- Keine Verlagsinformationen verfügbar
- Artikel merken
Bacteriology is the branch and specialty of biology that studies the morphology, ecology, genetics, identification, classification and biochemistry of bacteria and many other aspects related to them. Bacteriology is important in medicine, public health and sanitation, agriculture, the food industry and industry. The importance of bacteriology is undeniable; indeed, the study of the action of bacteria in health and disease, inside and outside the animal body, has revealed so many new facts. Major advances in bacteriology over the past century have led to the development of many effective vaccines (e.g., pneumococcal polysaccharide vaccine, diphtheria toxoid, and tetanus toxoid) as well as other vaccines (e.g. (e.g. vaccines against cholera, typhoid and plague) which are less effective or which have side effects. This book is a review of medically important aspects of bacteriology and covers both basic and clinical aspects of bacteriology and also deals with important infectious diseases caused by pathogenic bacteria. This book presents current and medically important information in rapidly evolving areas of bacteriology.
Dr. Hamidreza Honarmand has worked on several research projects in the areas of pathogenesis and diagnosis of infectious diseases and has published numerous articles in reputable journals.
| Erscheinungsdatum | 05.05.2024 |
|---|---|
| Sprache | englisch |
| Maße | 152 x 229 mm |
| Gewicht | 745 g |
| Themenwelt | Naturwissenschaften ► Biologie ► Allgemeines / Lexika |
| Naturwissenschaften ► Biologie ► Mikrobiologie / Immunologie | |
| Schlagworte | Bactériologie médicale |
| ISBN-10 | 620-7-50756-8 / 6207507568 |
| ISBN-13 | 978-620-7-50756-6 / 9786207507566 |
| Zustand | Neuware |
| Informationen gemäß Produktsicherheitsverordnung (GPSR) | |
| Haben Sie eine Frage zum Produkt? |
Mehr entdecken
aus dem Bereich
aus dem Bereich
Buch | Softcover (2024)
Wiley-VCH (Verlag)
CHF 55,85
Band 2: Elektrizität, Optik und Wellen
Buch | Softcover (2022)
Wiley-VCH (Verlag)
CHF 55,85
Vom Ursprung der Sexualitat zum modernen Menschen
Buch | Softcover (2025)
UTB (Verlag)
CHF 54,60


